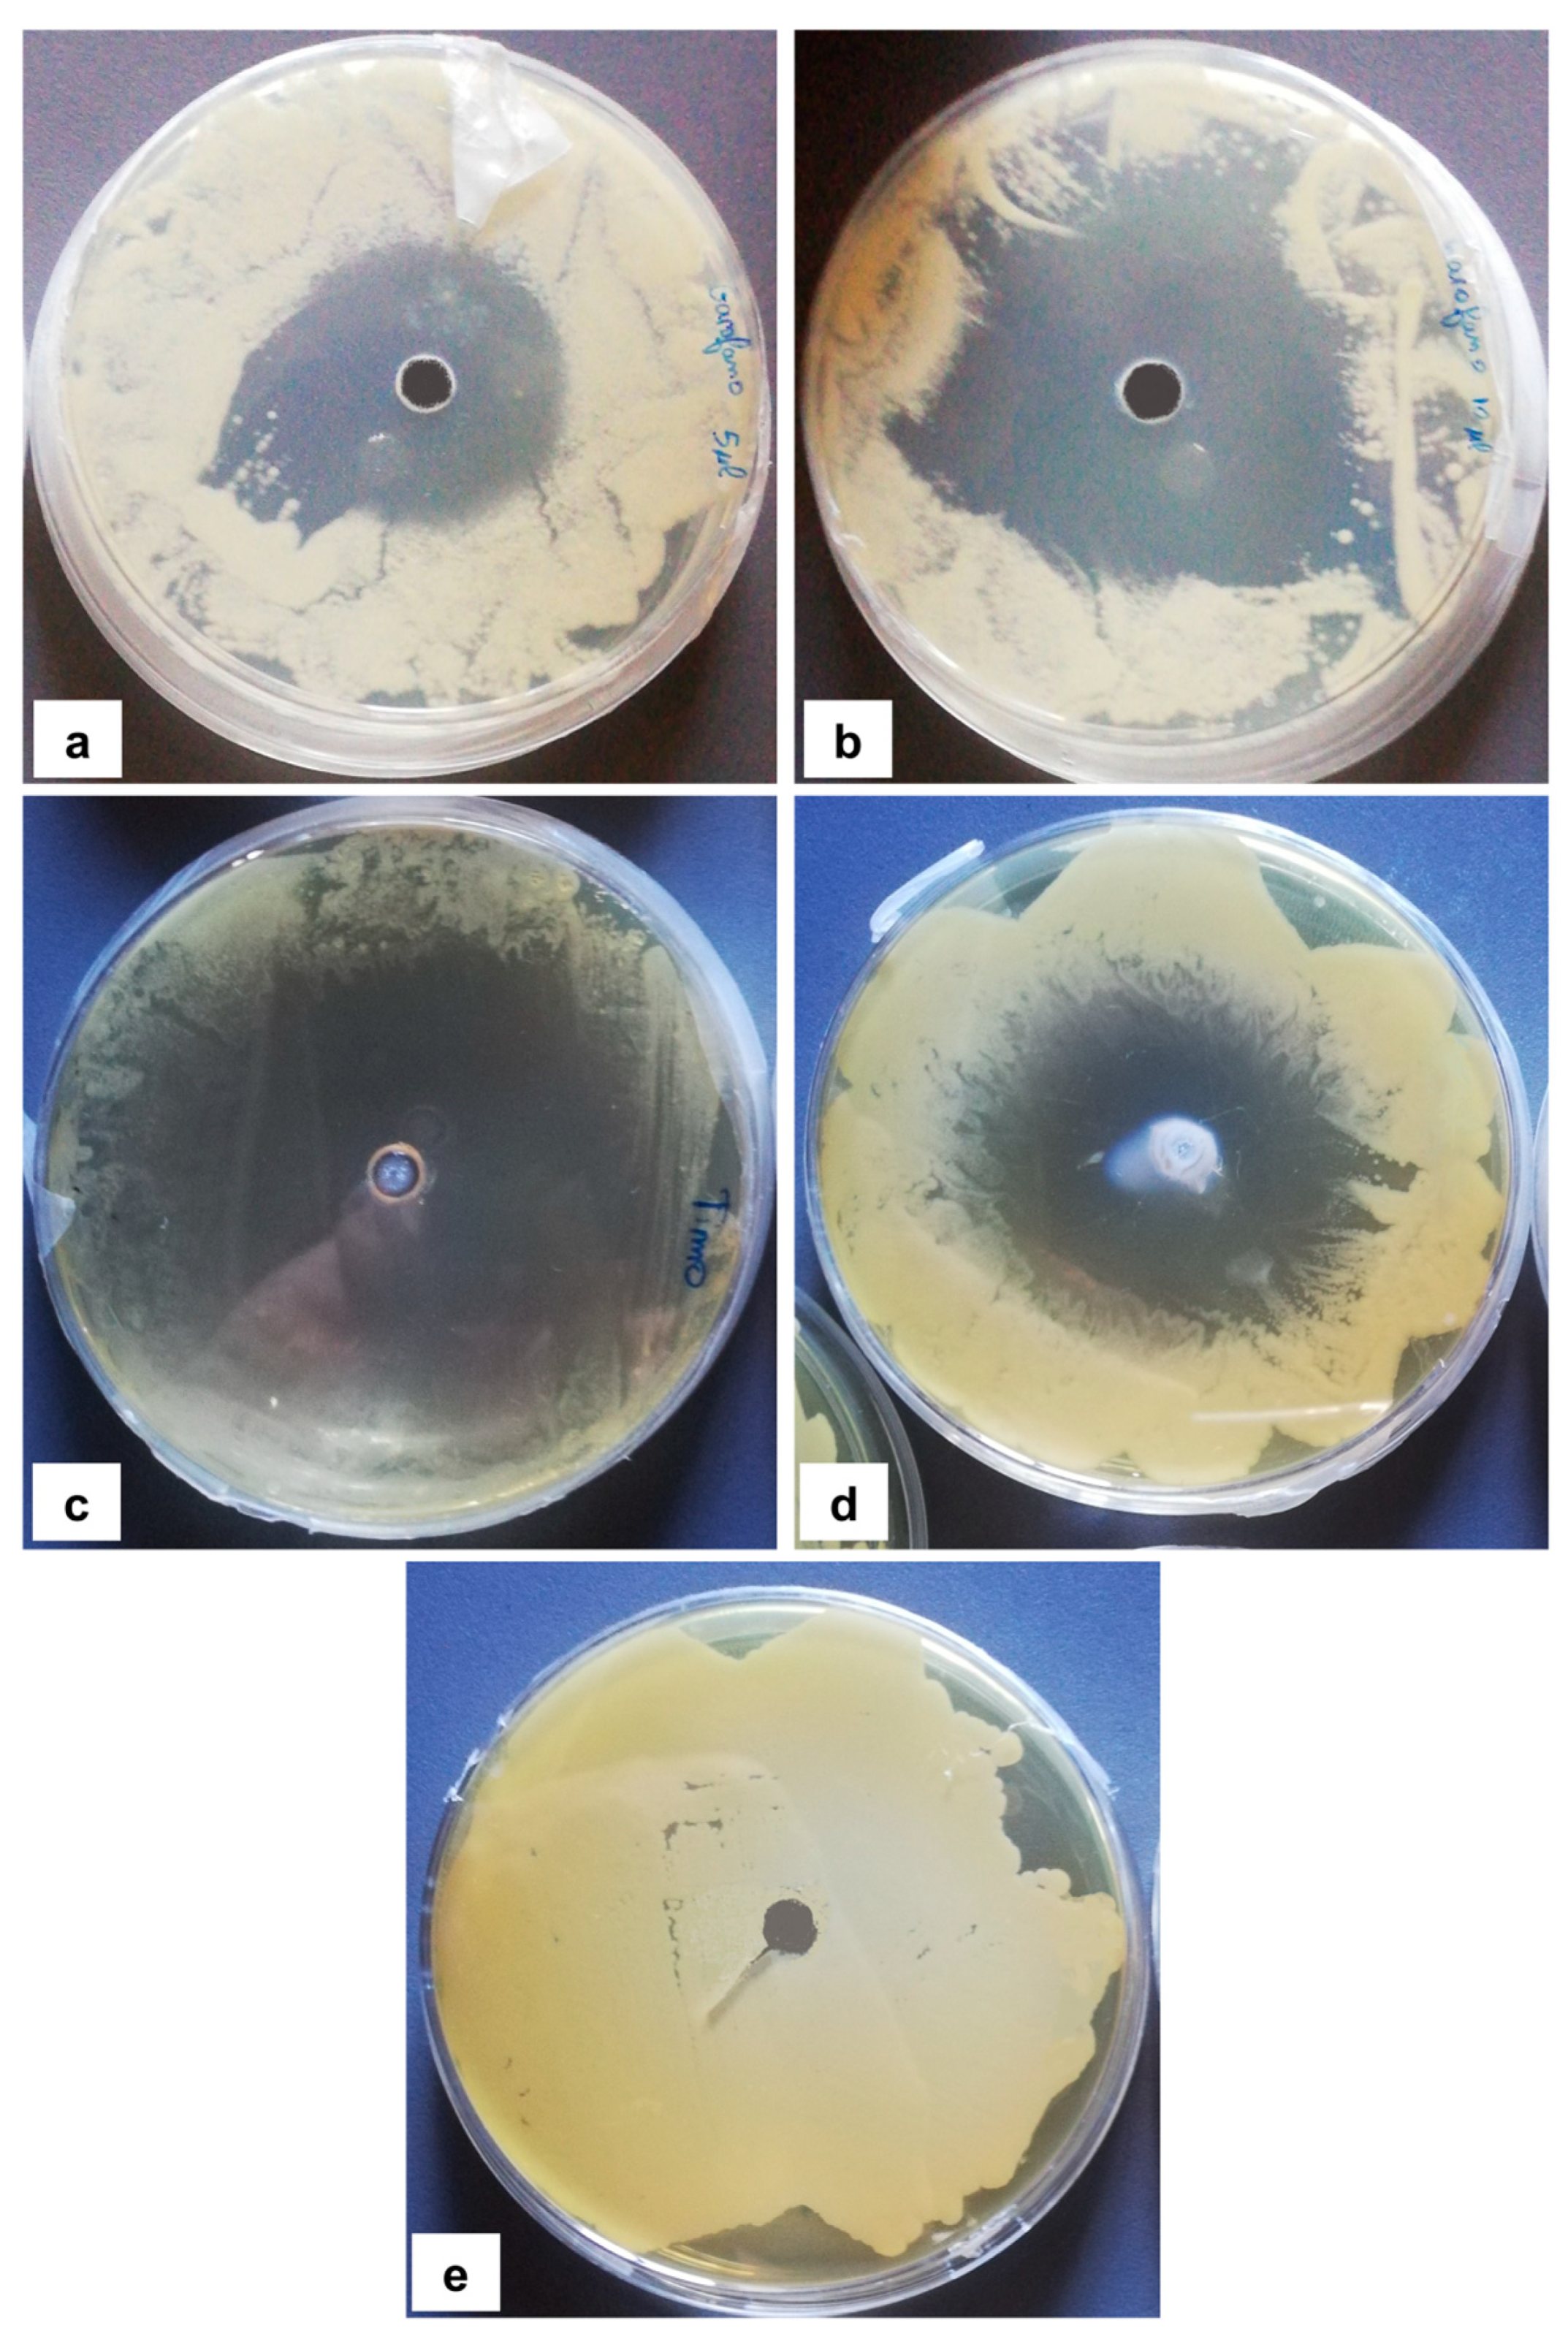
Jof 09 01054 g002

Fungal Biodeterioration and Preservation of Miniature Artworks
Abstract
:1. Introduction
2. Materials and Methods
2.1. Artwork Description and Conservation Conditions
2.2. Sampling and Microbial Isolation
2.3. Phenotypic Characterization and Molecular Identification of Fungal Isolates
2.4. Approach to Preserve Miniature Artworks
2.4.1. Antifungal Assay
2.4.2. Susceptibility of a Biodeterioration Agent to Anaerobiosis, Moisture, and Thyme Essential Oil
3. Results
3.1. Characterization and Identification of Biodeterioration Agents
3.2. Approach to Preserve the Miniature Artworks in Shells
3.2.1. In Vitro Antifungal Activity of Essential Oil
3.2.2. Anaerobiosis, Moisture, and Essential Oil Inhibition Effectiveness in In Vitro and In Vivo Tests
4. Discussion
Author Contributions
Funding
Data Availability Statement
Acknowledgments
Conflicts of Interest
References
- Hueck, H.J. The Biodeterioration of Materials—An Appraisal. In Biodeterioration of Materials; Walters, A.H., Elphick, J.S., Eds.; Elsevier: London, UK, 1968; pp. 6–12. [Google Scholar]
- Sabatini, L.; Sisti, M.; Campana, R. Evaluation of fungal community involved in the biodeterioration process of wooden artworks and canvases in Montefeltro area (Marche, Italy). Microbiol. Res. 2018, 207, 203–210. [Google Scholar] [CrossRef]
- Shirakawa, M.A.; Gaylarde, C.C.; Gaylarde, P.M.; Vanderley, J.; Gambale, W. Fungal colonization and succession on newly painted buildings and the effect of biocide. FEMS Microbiol. Ecol. 2002, 39, 165–173. [Google Scholar] [CrossRef]
- Malathi, S.; Devanathan, J. Biodeterioration of fabric paints by fungal species and their control using antifungal agent. Int. J. Adv. Res. Biol. Sci. 2017, 4, 1–4. [Google Scholar]
- Cifferi, O. Microbial degradation of paintings. Appl. Environ. Microbiol. 1999, 65, 879–885. [Google Scholar] [CrossRef]
- Poyatos, F.; Morales, F.; Nicholson, A.W.; Giordano, A. Physiology of biodeterioration on canvas paintings. J. Cell Physiol. 2018, 233, 2741–2751. [Google Scholar] [CrossRef] [PubMed]
- Caneva, G.; Nugari, M.P.; Salvadori, O. La Biología en la Restauración. In Hondarribia (Guipúzcoa); Nerea, Ed.; Andalusian Institute of Historical Heritage: Sevilla, Spain, 2000; p. 277. [Google Scholar]
- Crispim, C.A.; Gaylarde, C.C. Cyanobacteria and biodeterioration of cultural heritage: A review. Microb. Ecol. 2005, 49, 1–9. [Google Scholar] [CrossRef] [PubMed]
- Warscheid, T. Impacts of microbial biofilms in the deterioration of inorganic building materials and their relevance for the conservation practice. Restorat. Build. Monum. 1996, 2, 493–504. [Google Scholar] [CrossRef]
- Ortega-Calvo, J.J.; Arino, X.; Stal, L.J.; Saiz-Jimenez, C. Cyanobacterial sulfate accumulation from black crusts of a historic building. Geomicrobiol. J. 1994, 12, 15–22. [Google Scholar] [CrossRef]
- Kadaifciler, D.G. Bioaerosol assessment in the library of Istanbul University and fungal flora associated with paper deterioration. Aerobiologia 2017, 33, 151. [Google Scholar] [CrossRef]
- Zotti, M.; Ferroni, A.; Calvini, P. Microfungal biodeterioration of historic paper: Preliminary FTIR and microbiological analyses. Int. Biodeterior. Biodegrad. 2008, 62, 186–194. [Google Scholar] [CrossRef]
- Pinzari, F.; Pasquariello, G.; De Mico, A. Biodeterioration of paper: A SEM study of fungal spoilage reproduced under controlled conditions. Macromol. Symp. 2006, 238, 57–66. [Google Scholar] [CrossRef]
- Soares, F.L., Jr.; Melo, I.S.; Dias, A.C.; Andreote, F.D. Cellulolytic bacteria from soils in harsh environments. World J. Microbiol. Biotechnol. 2012, 28, 2195–2203. [Google Scholar] [CrossRef] [PubMed]
- Naji, K.M.; Abdullah, Q.Y.M.; A.L.-Zaqri, A.Q.M.; Alghalibi, S.M. Evaluating the biodeterioration enzymatic activities of fungal contamination isolated from some ancient yemeni mummies preserved in the National Museum. Biochem. Res. Int. 2014, 2014, 481508. [Google Scholar] [CrossRef] [PubMed]
- Osman, M.E.S.; El Shaphy, A.A.E.N.; Meligy, D.A.; Ayid, M.M. Survey for fungal decaying archaeological wood and their enzymatic activity. Int. J. Conserv. Sci. 2014, 5, 295–308. [Google Scholar]
- Doménech-Carbó, M.T.; Osete-Cortina, L.; de la Cruz-Cañizares, J.; Bolívar-Galiano, F.; Romero-Noguera, J.; Fernández-Vivas, M.A.; Martín-Sáncez, I. Study on the microbiodegradation of terpenoid resins-based varnishes from easel painting using pyrolysisgas chromatography-mass spectrometry and gas chromatography-mass spectrometry. Anal. Bioanal. Chem. 2006, 385, 1265–1280. [Google Scholar] [CrossRef]
- López-Miras, M.; Piñar, G.; Romero-Noguera, J.; Bolívar-Galiano, F.; Ettenauer, J.; Sterflinger, K.; Martín-Sánchez, I. Microbial communities adhering to the obverse and reverse sides of an oil painting on canvas: Identification and evaluation of their biodegradative potential. Aerobiologia 2013, 29, 301–314. [Google Scholar] [CrossRef]
- Ortiz-Miranda, A.S.; Doménech-Carbó, A.; Doménech-Carbó, M.T.; Osete-Cortina, L.; Bolívar-Galiano, F.; Martín-Sánchez, I. Analyzing chemical changes in verdigris pictorial specimens upon bacteria and fungi biodeterioration using voltammetry of microparticles. Herit. Sci. 2017, 5, 8. [Google Scholar] [CrossRef]
- Sterflinger, K. Fungi: Their role in deterioration of cultural heritage. Fungal Biol. Rev. 2010, 24, 47–55. [Google Scholar] [CrossRef]
- Lee, Y.; Martín-Rey, S.; Osete-Cortina, L.; Martín-Sánchez, I.; Bolívar-Galiano, F.; Doménech-Carbó, M.T. Evaluation of a gelatin-based adhesive for historic paintings that incorporates citronella oil as an eco-friendly biocide. J. Adhes. Sci. Technol. 2018, 32, 2320–2349. [Google Scholar] [CrossRef]
- Pepe, O.; Sannino, L.; Palomba, S.; Anastasio, M.; Blaiotta, G.; Villani, F.; Moschetti, G. Heterotrophic microorganisms in deteriorated medieval wall paintings in southern Italian churches. Microbiol. Res. 2010, 165, 21–32. [Google Scholar] [CrossRef]
- Pepe, O.; Palomba, S.; Sannino, L.; Blaiotta, G.; Ventorino, V.; Moschetti, G.; Villani, F. Characterization in the archaeological excavation site of heterotrophic bacteria and fungi of deteriorated wall painting of herculaneum in Italy. J. Environ. Biol. 2011, 32, 241–250. [Google Scholar]
- White, T.J.; Bruns, T.; Lee, S.; Taylor, J. Amplification and Direct Sequencing of Fungal Ribosomal RNA Genes for Phylogenetics. In PCR Protocols; A Guide to Methods and Applications; Innis, M.A., Gelfand, D.H., Sninsky, J.J., White, T.J., Eds.; Academic Press: San Diego, CA, USA, 1990; pp. 315–322. [Google Scholar]
- Sannino, F.; Nuzzo, A.; Ventorino, V.; Pepe, O.; Piccolo, A. Effective degradation of organic pollutants in aqueous media by microbial strains isolated from soil of a contaminated industrial site. Chem. Biol. Technol. Agric. 2016, 3, 2. [Google Scholar] [CrossRef]
- Romano, I.; Ventorino, V.; Ambrosino, P.; Testa, A.; Chouyia, F.E.; Pepe, O. Development and application of low-cost and eco-sustainable bio-stimulant containing a new plant growth promoting strain Kosakonia pseudosacchari TL13. Front. Microbiol. 2020, 11, 2044. [Google Scholar] [CrossRef] [PubMed]
- Ventorino, V.; Parillo, R.; Testa, A.; Aliberti, A.; Pepe, O. Chestnut biomass biodegradation for sustainable agriculture. BioResources 2013, 8, 4647–4658. [Google Scholar] [CrossRef]
- Magaldi, S.; Mata-Essayag, S.; Hartung De Capriles, C.; Perez, C.; Colella, M.T.; Olaizola, C.; Ontiveros, Y. Well diffusion for antifungal susceptibility testing. Int. J. Infect. Dis. 2004, 8, 39–45. [Google Scholar] [CrossRef] [PubMed]
- Di Mola, I.; Ventorino, V.; Cozzolino, E.; Ottaiano, L.; Romano, I.; Duri, L.G.; Pepe, O.; Mori, M. Biodegradable mulching vs. traditional polyethylene film for sustainable solarization: Chemical properties and microbial community response to soil management. Appl. Soil Ecol. 2021, 163, 103921. [Google Scholar] [CrossRef]
- Rosado, T.; Silva, M.; Dias, L.; Candeias, A.; Gil, M.; Mirão, J.; Pestana, J.; Caldeira, A.T. Microorganisms and the integrated conservation-intervention process of the renaissance mural paintings from Casas Pintadas in Évora—Know to act, act to preserve. J. King Saud Univ. Sci. 2017, 29, 478–486. [Google Scholar] [CrossRef]
- Romero, S.M.; Giudicessi, S.L.; Viatle, R.G. Is the fungus Aspergillus a threat to cultural heritage? J. Cult. Herit. 2021, 51, 107–124. [Google Scholar] [CrossRef]
- Palla, F.; Bruno, M.; Mercurio, F.; Tantillo, A.; Rotolo, V. Essential oils as natural biocides in conservation of cultural heritage. Molecules 2020, 25, 730. [Google Scholar] [CrossRef]
- Andlar, M.; Rezić, T.; Marđetko, N.; Kracher, D.; Ludwig, R.; Šantek, B. Lignocellulose degradation: An overview of fungi and fungal enzymes involved in lignocellulose degradation. Eng. Life Sci. 2018, 18, 768–778. [Google Scholar] [CrossRef] [PubMed]
- Ljaljević-Grbić, M.; Stupar, M.; Vukojević, J.; Maricić, I.; Bungur, N. Molds in museum environments: Biodeterioration of art photographs and wooden sculptures. Arch. Biol. Sci. 2013, 65, 955–962. [Google Scholar] [CrossRef]
- Liu, Z.; Zhang, Y.; Zhang, F.; Hu, C.; Liu, G.; Pan, J. Microbial community analyses of the deteriorated storeroom objects in the Tianjin Museum using culture-independent and culture-dependent approaches. Front. Microbiol. 2018, 9, 802. [Google Scholar] [CrossRef]
- Paiva de Carvalho, H.; Mesquita, N.; Trovão, J.; Rodríguez, S.F.; Pinheiro, A.C.; Gomes, V.; Alcoforado, A.; Gil, F.; Portugal, A. Fungal contamination of paintings and wooden sculptures inside the storage room of a museum: Are current norms and reference values adequate? J. Cult. Herit. 2018, 34, 268–276. [Google Scholar] [CrossRef]
- Borrego, S.; Molina, A. Fungal assessment on storerooms indoor environment in the National Museum of Fine Arts, Cuba. Air Qual. Atmos. Health 2019, 12, 1373–1385. [Google Scholar] [CrossRef]
- Sparacello, S.; Gallo, G.; Faddetta, T.; Megna, B.; Nicotra, G.; Bruno, B.; Giambra, B.; Palla, F. Thymus vulgaris essential oil and hydro-alcoholic solutions to counteract wooden artwork microbial colonization. Appl. Sci. 2021, 11, 8704. [Google Scholar] [CrossRef]
- Sanmartín, P.; DeAraujo, A.; Vasanthakumar, A. Melding the old with the new: Trends in methods used to identify, monitor, and control microorganisms on cultural heritage materials. Microb. Ecol. 2018, 76, 64–80. [Google Scholar] [CrossRef] [PubMed]
- Rotolo, V.; Barresi, G.; Carlo, E.; Giordano, A.; Lombardo, G.; Crimi, E.; Costa, E.; Bruno, M.; Palla, F. Plant extracts as green potential strategies to control the biodeterioration of cultural heritage. Int. J. Conserv. Sci. 2016, 7, 839–846. [Google Scholar]
- Borrego, S.; Valdés, O.; Vivar, I.; Lavin, P.; Guiamet, P.; Battistoni, P.; Gómez de Saravia, S.; Borges, P. Essential oils of plants as biocides against microorganisms isolated from Cuban and Argentine Documentary Heritage. Int. Sch. Res. Not. 2012, 2012, 826786. [Google Scholar] [CrossRef]
- Fierascu, I.; Ion, R.M.; Radu, M.S.O.; Bunghez, I.R.; Avramescu, S.M.; Fierascu, R.C. Comparative study of antifungal effect of natural extracts and essential oils of Ocimum basilicum on selected artefacts. Rev. Roum. Chim. 2014, 59, 207–211. [Google Scholar]
- Sanchis, C.M.; Bosch-Roig, P.; Moliner, B.C.; Miller, A.Z. Antifungal properties of oregano and clove volatile essential oils tested on biodeteriorated archaeological mummified skin. J. Cult. Herit. 2023, 61, 40–47. [Google Scholar] [CrossRef]
- Boniek, D.; Bonadio, L.; Damaceno, Q.S.; Dos Santos, A.F.B.; de Resende Stoianoff, M.A. Occurrence of Aspergillus niger strains on a polychrome cotton painting and their elimination by anoxic treatment. Can. J. Microbiol. 2020, 66, 586–592. [Google Scholar] [CrossRef] [PubMed]
- Boniek, D.; Dos Santos, A.F.B.; de Resende Stoianoff, M.A. Detection of Cladosporium spinulosum on an engraving by Rembrandt and susceptibility profile to eco-friendly antifungal treatments. J. Basic Microbiol. 2023, 63, 1085–1094. [Google Scholar] [CrossRef] [PubMed]
- Kosel, J.; Kavčič, M.; Legan, L.; Retko, K.; Ropret, P. Evaluating the xerophilic potential of moulds on selected egg tempera paints on glass and wooden supports using fluorescent microscopy. J. Cult. Herit. 2021, 52, 44–54. [Google Scholar] [CrossRef]
- Piñar, G.; Tafer, H.; Sterflinger, K.; Pinzari, F. Amid the possible causes of a very famous foxing: Molecular and microscopic insight into Leonardo da Vinci’s self-portrait. Environ. Microbiol. Rep. 2015, 7, 849–859. [Google Scholar] [CrossRef] [PubMed]
- DM 10/05/2001 (2014); Atto di Indirizzo Sui Criteri Tecnico-Scientifici e Sugli Standard di Funzionamento e Sviluppo dei Musei; Supplemento ordinario Gazzetta Ufficiale 244 del 19/10/2001. Ministry for Cultural Heritage and Activities: Rome, Italy, 2014.

| Sampling Point | Colony Morphology | Colony Morphology Description | Microphotograph | Micromorphology Description | |
|---|---|---|---|---|---|
| DRBC | PCA | ||||
| NDDC1 | ![]() | ![]() | Mycelium white at the edges and green (DRBC) or yellow (PCA), slightly elevated, entire margin. | ![]() | Vesicles spherical to sub-spherical, metulae and phialides biseriate, conidia globose to sub-globose. |
| NDDC2 | ![]() | ![]() | Mycelium white at the edges and green (DRBC) or yellow (PCA), slightly elevated, entire margin. | ![]() | Vesicles spherical to sub-spherical, metulae and phialides biseriate, conidia globose to sub-globose. |
| NDDC3 | ![]() | ![]() | Mycelium white at the edges and green (DRBC) or yellow (PCA), slightly elevated, entire margin. | ![]() | Vesicles spherical to sub-spherical, metulae and phialides biseriate, conidia globose to sub-globose. |
| Essential Oil | Inhibition Area (mm) | |
|---|---|---|
| 5 µL | 10 µL | |
| Basil | 28.9 ± 2.5 d | 31.5 ± 3.4 d |
| Cloves | 47.0 ± 2.4 c | 67.6 ± 1.6 b |
| Eucalyptus | n.a. | n.a. |
| Fennel | 11.2 ± 1.8 e | 30.4 ± 2.7 d |
| Lavender | n.a. | n.a. |
| Pine | n.a. | n.a. |
| Thyme | 64.4 ± 1.6 b | 80.7 ± 1.4 a |
| Anaerobiosis | Aerobiosis | |||
|---|---|---|---|---|
| 90% RH | 25% RH | 90% RH | 25% RH | |
| Presence of thyme | − | − | + | − |
| Absence of thyme | + | − | + | − |
Disclaimer/Publisher’s Note: The statements, opinions and data contained in all publications are solely those of the individual author(s) and contributor(s) and not of MDPI and/or the editor(s). MDPI and/or the editor(s) disclaim responsibility for any injury to people or property resulting from any ideas, methods, instructions or products referred to in the content. |
© 2023 by the authors. Licensee MDPI, Basel, Switzerland. This article is an open access article distributed under the terms and conditions of the Creative Commons Attribution (CC BY) license (https://creativecommons.org/licenses/by/4.0/).
Share and Cite
Ventorino, V.; La Storia, A.; Robertiello, A.; Corsi, S.; Romano, I.; Sannino, L.; Pepe, O. Fungal Biodeterioration and Preservation of Miniature Artworks. J. Fungi 2023, 9, 1054. https://doi.org/10.3390/jof9111054
Ventorino V, La Storia A, Robertiello A, Corsi S, Romano I, Sannino L, Pepe O. Fungal Biodeterioration and Preservation of Miniature Artworks. Journal of Fungi. 2023; 9(11):1054. https://doi.org/10.3390/jof9111054
Chicago/Turabian StyleVentorino, Valeria, Antonietta La Storia, Alessandro Robertiello, Silvia Corsi, Ida Romano, Luigi Sannino, and Olimpia Pepe. 2023. "Fungal Biodeterioration and Preservation of Miniature Artworks" Journal of Fungi 9, no. 11: 1054. https://doi.org/10.3390/jof9111054
APA StyleVentorino, V., La Storia, A., Robertiello, A., Corsi, S., Romano, I., Sannino, L., & Pepe, O. (2023). Fungal Biodeterioration and Preservation of Miniature Artworks. Journal of Fungi, 9(11), 1054. https://doi.org/10.3390/jof9111054









